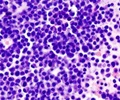
Multiple Myeloma / Plasma Cell Myeloma–Symptoms-Treatment-Prognosis-Support Group

Cyclophosphamide Medication Information
Learn everything you need to know about Cyclophosphamide-pronunciation, uses, dosage guidelines, indications, and when to take or avoid it.
Get up-to-date information on side effects, precautions, warnings, and proper storage to ensure safe usage.
Explore Cyclophosphamide brand names commonly used in India and internationally, along with detailed pricing information. Consult your healthcare provider for tailored medical advice.
Generic Name : Cyclophosphamide Pronunciation : sye kloe foss' fa mideBrand Names or Trade Names of Cyclophosphamide
India :
Neophos |
Oncomide |
Oncophos |
Endoxan-Asta (200mg) |
Ledoxan (500 mg) |
Endoxan -N |
Cycloxan (500 mg) |
CTX-GLS 200 mg |
Cydoxan (1 gm) |
Cycloxan
International :
Cytoxan, Neosar
Why is Cyclophosphamide Prescribed? (Indications)
This medication is an antineoplastic agent, prescribed for many types of cancers like lymphatic cancer, cancer of white blood cells and plasma cells, etc,. It slows or stops the growth of cancer cells in your body.When should Cyclophosphamide not be taken? (Contraindications)
It may cause bladder bleeding in patients with bone-marrow defect, acute infection, and drug- or radiation-induced urinary tract toxicity, harmful to pregnancy and lactation.What is the dosage of Cyclophosphamide?
Adults and Children- Treatment of Malignant Diseases- The recommended dose is 40 to 50 mg/kg given intravenously in divided doses over a period of 2 to 5 days.Treatment of Nonmalignant Diseases- An oral dose of 2.5 to 3 mg/kg daily for a period of 60 to 90 days is recommended.
How should Cyclophosphamide be taken?
It comes as a tablet to take by mouth, on an empty stomach.It also comes as a solution for injection to be administered by a healthcare provider into the vein.
What are the warnings and precautions for Cyclophosphamide?
•It may cause blood disorders.• Caution should be exercised in elderly or debilitated, diabetic patients, who have undergone adrenal removal operation.
• Monitor blood profile and presence of RBCs in urine regularly.
• Maintain adequate hydration and frequent urination to reduce the risk of cystitis.
What are the side effects of Cyclophosphamide?
Heart- Acute cardiac toxicity, heart failure, blood in the pericardium, fluid accumulation, irreversible destruction of heart muscle, inflammation of pericardium.Central Nervous System- Lack of energy, general discomfort.
Skin- Hair loss, nail changes, skin pigmentation, skin rash, toxic epidermal blistering.
Gastrointestinal- Abdominal discomfort and pain, loss of appetite, diarrhea, bleeding in colon, sore throat, nausea, vomiting.
Hormone- Syndrome of inappropriate anti- diuretic hormone hyper secretion.
Genitourinary- Absence of a menstrual period associated with decreased estrogen and increased gonadotropin secretion, atypical urinary bladder epithelial cells in the urine, absence of sperm, urinary bladder inflammation, blood in urine, impairment of fertility, cyst in ovary, death of tubular cells , urinary bladder cyst.
Liver- Jaundice.
Blood-Lymphatic- Decrease in all types of blood cells with fever.
Hypersensitivity- Systemic vasodilatation which results in low blood pressure, including death.
Respiratory- Scarring of both lungs, scarring and thickening of the lung tissues.
Miscellaneous- Infections, cancers caused by treatment with radiation or chemotherapy.
What are the other precautions for Cyclophosphamide?
It may cause absence of menstrual period in women.What are the storage conditions for Cyclophosphamide?
Store at 25�C. Store it in air tight container and keep away from children.Schedule : G
Drugs that are to be used only under medical supervision.
MEDINDIA
Email